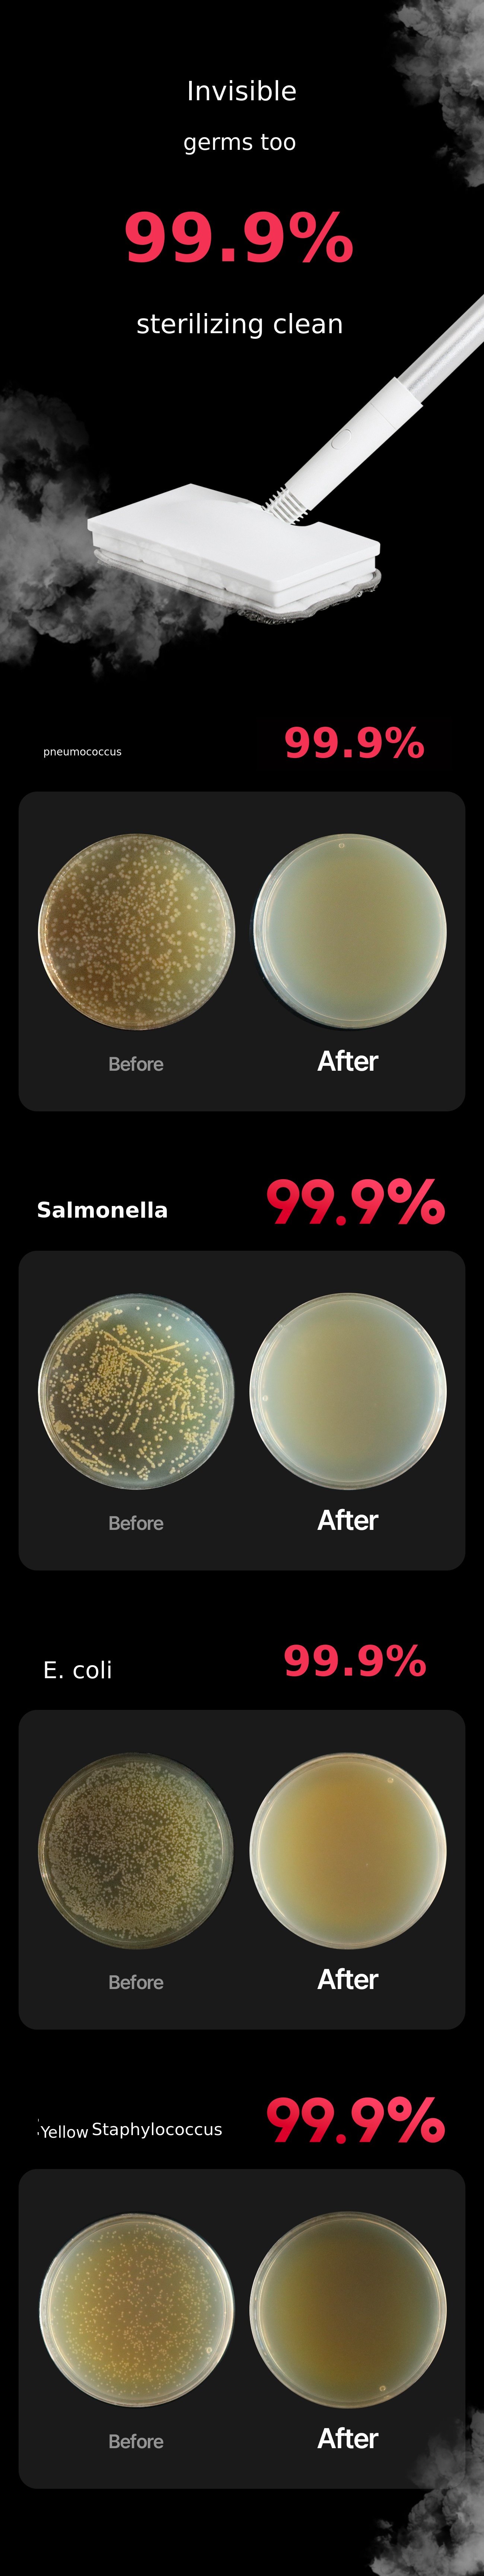

Hello, supporters. We are Hubic, a brand that constantly contemplates small values essential for a convenient life and proposes a better lifestyle.
The newly introduced Hubic steam cleaner effectively cleans various spaces such as floors, kitchens, and bathrooms using high-temperature steam, allowing for hygienic cleaning without chemical detergents.
In addition, to enhance user satisfaction, we have prepared a variety of convenient accessory nozzles and stands, available exclusively on Wadiz with powerful benefits. We kindly ask for your support and encouragement.
Hubic is a brand that grows together with supporters by communicating and strictly verifying quality and safety, so that anyone can use our products safely and conveniently anytime, anywhere, and feel secure in daily life. Thank you.
Reason for Wadiz Funding &
Plan for Use of Funding
We prepared this project to have the valuable opportunity to receive verification and feedback from supporters who view our story and products most sincerely and communicate actively, and to promote the Hubic brand. All funds from supporters who trust and support us will be used for after-sales service, improvement, and development costs of the product. We will do our best to continue to bring you even better products in the future.
huaco Co.,Ltd
